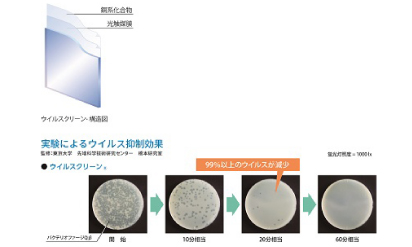
抗菌・抗ウイルスガラス「ウイルスクリーンα」

経営課題解決ツール・サービス
医療・介護の経営課題の解決に特化したツール・サービスのご案内
医療機関・薬局・介護事業者の多様化する経営課題解決に役立つツール・サービスを集結して「医療機関等と各企業のソリューション・ツールをダイレクトにつなぐプラットフォーム」を設けました。
弊社を介することなく、各企業とダイレクトに当事者間でスムーズにご確認いただくことが可能です。
-

特定社会保険労務士対応・医療関係で勤務する人たちの管理者に対する労務ご相談サービス
ドラフト労務管理事務所対象施設医療関係で勤務する人たちの管理者期待効果リスクを予見したうえでの問題解決人材派遣会社の労務相談や働き方改革推進支援センター等で労務相談を10年以上担当した特定社会保険労務士がリスクを分析しながら労務に関する諸問題の改善点を提案します。
また、近年社会問題化しているハラスメント防止に関する職員教育も適時実施中。問題解決のドラフトをご提案させてください。 -

匿名型ハラスメント相談受付システム
株式会社パイプドビッツ対象施設病院・介護施設・薬局運営企業期待効果安心して運用できる相談受付窓口匿名型ハラスメント相談受付システムは、職場のハラスメント防止対策を支援するWebシステムです。パワーハラスメント防止対策を義務化する法律が成立した現在、企業ではその対応に必要な整備が求められています。 -

医療機関・介護施設等の「働きやすい職場づくり」サポート
社会保険労務士法人プラスワン労務対象施設東京23区・埼玉南部の医療機関・介護施設期待効果コンプライアンス強化/モチベーション向上「エッセンシャル・ワーカー」と言われ、社会になくてはならない仕事である一方、長時間労働や低い定着率など課題が多い医療・介護の現場。そうした大変な職場環境を改善し、働きやすく、真に働き甲斐のもてる職場づくりをお手伝いします。 -

多職種連携ソリューション「Team」
株式会社アルム対象施設訪問介護・看護事業所や保健所、医療機関期待効果スムーズな情報共有で業務効率化・最適化医療・介護サービスをシームレスに繋ぎ、多職種連携をサポートするソリューションです。タブレット端末で申し送り事項や利用者状況などを記録し、Teamクラウドシステム上で多職種間でのリアルタイムな情報共有を可能にすることにより、訪問事業における業務効率化とスムーズな多職種連携を実現します。 -

医療機関専門の社会保険労務士が支援「病院・クリニックを守る就業規則」作成・見直しサービス
社会保険労務士法人NAGATOMO対象施設首都圏に拠点のある病院・クリニック・薬局期待効果労務リスク対策/コンプライアンス強化メンタルヘルス・パワハラ・いじめ・職員の問題行動…、従来の職場では想定できない労務トラブルが頻発し、医療機関が職員への対応に苦慮するケースが多く見られます。社会保険労務士法人NAGATOMOでは、最新の法改正状況に対応させることはもちろんのこと、医療機関からこれまでにお受けした多くの労務相談に基づいて、医療機関が自院の経営を守るために必要とされるリスク対応型の就業規則を作成します。 -

eMamo(イーマモ)次世代見守りサービス
株式会社リンクジャパン対象施設介護施設期待効果入所者の安全管理、業務効率化eMamoは各種センサーの活用により、入所者の体調や居室の異変を早期発見できるIOT見守りサービスです。各種センサーは工事不要で後付け可能です。クラウド型なのでどこからでも管理ツールにアクセスできます。低コストで簡単にできる見守り&業務効率化サービスです。 -

人事労務のITC化支援を通じ労務管理業務の生産性向上をサポート 労務関連相談も提携弁護士と連携対応
社会保険労務士法人ロウムテック対象施設全国対応、従業員数数50人以上期待効果労務の生産性アップ及び処遇改善加算支援弊社は医療介護に特化した社労士の団体「医療介護経営研究会」https://www.c-sr.jp/に所属し、医療介護業界特有の様々な労務関連課題の解決に全力で取り組んでおります。勤怠管理クラウドの導入コンサルティングから給与計算・各種保険手続・相談業務までご要望に合わせ対応致します。特に業務のITC化についてはRPA・VBA等の自動化の支援も致します。 -

介護施設・医療機関等の「働き方改革支援サービス~ネットde顧問」
社会保険労務士事務所 労務サポート対象施設名古屋市・愛知県西部の介護施設・医療機関期待効果生産性の向上/働き方改革企業様⇔社労士事務所を繋ぐ『業務支援システム』です。総務担当者の負担軽減や従業員の管理・周知がスムーズに行えます。 -

『医療機関向けウェブサービスMeDaCa PRO』患者アプリと繋がるコミュニケーションツール
メディカルデータカード株式会社対象施設慢性疾患をはじめ健康診断実施施設期待効果疾患コントロールと患者満足度向上患者の臨床検査結果にコメントをつけタイムリーに患者MeDaCaアプリに送信できます。また一斉や個別のメッセージ送信や、検査結果を患者と1画面で共有しながらの遠隔診療も可能なビデオ通話機能を備えた、患者と医療機関を繋ぐコミュニケーションツールです。セキュリティ面について、日本において医療情報システムの構築・運用を行う上で遵守すべき3省2ガイドラインを参照した運用を行っており安全にご利用いただけます。 -

こころの健診センター
株式会社パイプドビッツ対象施設1拠点に社員が50人以上いる事業者様期待効果高ストレス予備軍の早期発見「こころの健診センター」は、事業者が義務化で求められる実施体制の構築から運用までを支援するサービスです。事業者は、高セキュリティなクラウド環境でオンラインストレスチェックの実施から結果の管理・集団分析を実現できます。 -

介護保険システム ほのぼのNEXT/障害者総合支援法対応版 ほのぼのmore
NDソフトウェア株式会社対象施設介護保険事業者/障がい福祉事業者期待効果ICT化で人手不足解消と業務効率化UP介護保険制度および障害者総合支援法に対応した「ほのぼの」シリーズは、請求業務はもちろん、記録や計画書などをシステム化することで業務効率化などをサポートします。
体温計や血圧などバイタル機器との連動やタブレット端末による記録、センサー連携、話した言葉が文字化する新デジタルインカムなど業界トップシェアだから安心と満足をご提供できる体制は万全です。 -

真空ガラス「スペーシア」 健康や省エネに配慮した窓ガラス
日本板硝子株式会社対象施設病院・介護施設期待効果環境改善、コスト削減(省エネ)真空ガラス「スペーシア」は魔法瓶の原理を窓ガラスに応用した製品で、ガラスとガラスの間に真空層をつくることで、一枚ガラスの約4倍、一般的な複層ガラスの約2倍の断熱性能を実現しています。結露・寒さ・暑さ・省エネといったお悩みを窓ガラスで解決します。 -

パレットラインシリーズ(メディカルパレット(旧薬局パレット)/ からだパレット / 食事パレット
株式会社メディエイド対象施設医療機関、調剤薬局、介護施設、リハ施設等期待効果医療従事者と患者のコミュニケーション強化パレットラインシリーズは、医療従事者と患者・利用者様のオンライン上でのコミュニケーション強化をサポートいたします。メディカルパレットラインでは処方箋送信やオンライン服薬指導、受付管理、食事パレットラインでは栄養価計算や栄養士とのコミュニケーション、からだパレットラインではバイタルデータの記録や医療機関への共有などを行うことが可能です。PHRデータは弊社ライフパレットプラットフォームに保管されます。 -

労務関連の他、弁護士、司法書士、行政書士等11種の士業グループで法律サービスをワンストップで提供
社会保険労務士法人キャストグローバル対象施設関東・東北の医療機関、介護施設期待効果人事労務サポート、その他法律支援労務手続き、労務トラブル相談、就業規則、給与計算などの支援を人事労務のスペシャリストとしてサービス提供を行っております。11士業のグループ法人になるため、社労士以外の法律相談や手続きもワンストップで支援ができ、質の高い法務サービスの提供ができるため、どこに聞けば良いのかわからない、といったお困りごとも相談可能です。 -
抗菌・抗ウイルスガラス「ウイルスクリーンα」
日本板硝子株式会社対象施設病院・介護施設期待効果感染防止「ウイルスクリーンα」は、ガラス面に付着した細菌やウイルスの増殖を大幅に抑制する抗菌・抗ウイルスガラスです。病院や介護施設など飛沫感染や接触感染対策が求められる場所で、窓ガラスや間仕切り、衝立など様々な用途へご使用が可能です。 -

(処遇改善対応)福祉の職員15年経験者の社会保険労務士事務所
フクツル社会福祉士・社会保険労務士事務所対象施設介護サービス事業者、障害者福祉事業者期待効果処遇改善、就労トラブル解決、助成金活用障害者施設の介護職員・相談員、高齢者施設の介護職員、相談員、マネジメント、運営職員などを合わせて15年以上の経験あり、社会福祉士・介護福祉士・ケアマネジャーの有資格者として、貴施設の悩みに寄り添い問題解決を一緒に取り組む姿勢でお手伝いさせていただきます。福祉施設職員へのセミナーや研修講師の実績多数あり、一般職員・中間管理職・運営職それぞれの喜びや悩みが身に染みている社労士に是非ご相談ください。 -

医療関係者間コミュニケーションアプリ「Join」
株式会社アルム対象施設医療機関期待効果コミュニケーション促進、働き方改革に貢献医療関係者が高セキュリティ環境下でコミュニケーションをとることができるアプリです。標準搭載されたDICOMビューワーで医用画像を閲覧、チャットに共有することで、夜間休日などに院外にいる医師へのコンサルテーションツールとしての活用や、救急患者の転院の際の病院間連携・情報共有などに利用されています。日本ではじめて保険収載されたプログラム医療機器です。

